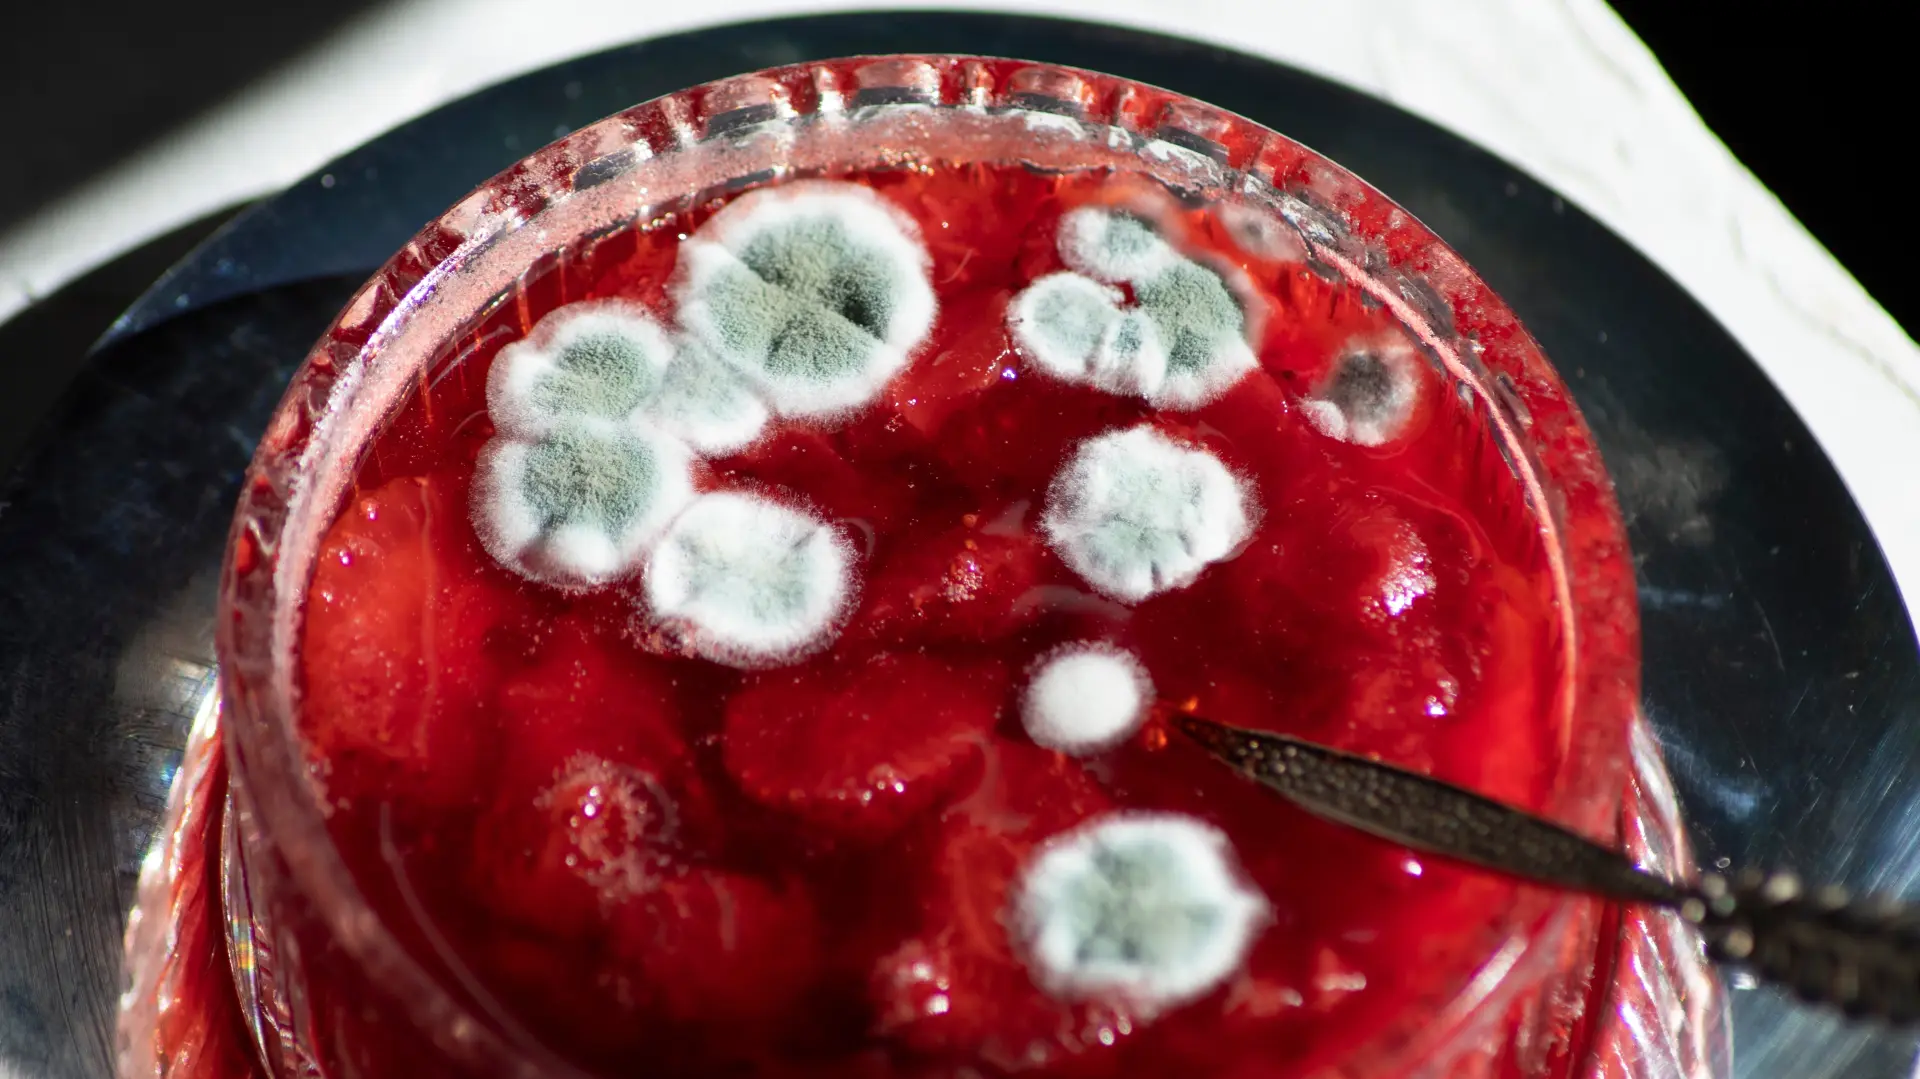

Spas za imuni sistem: Ukiseljeni beli luk će upotpuniti vašu zimnicu
Predstavljamo vam interesantni recept za ukiseljeni beli luk. Ovaj specijalitet je spas za vaš imuni sistem tokom jesenjih i zimskih dana.
 Foto: Shutterstock
Foto: ShutterstockNa Balkanu se uvek dosta pažnje poklanjalo pripremi zimnice i samoj zimnici, i retko koji dom nije imao bar jednu teglu ajvara ili turšije.
Kako vreme ide to je sve ređi slučaj zbog nedostatka vremena, ali i situacija kada je jeftinije kupiti zimnicu u prodavnici nego je spremati sam.
Ipak, postoje recepti koji ne mogu da se kupe, a jako su interesantni. Jedan od njih je zasigurno ukiseljeni beli luk.
Sastojci:
- Šolja belog vinskog sirćeta
- Kašičica soli
- Pola kašičice šećera
- Timijan
- Nekoliko zrna bibera
- Oljušteni čenovi belog luka

Priprema:
U manjoj šerpici zagrejte šećer, so i sirće, pa pustite da provri. Začinite i dok je još vruće prelite preko čenova belog luka koje ste složili gusto u prethodno sterilizovanu teglu.
Teglicu dobro zatvorite i držite na sobnoj temperaturi, čak i do dva meseca.
Sa ovakvim belim lukom možete eksperimentisati, a već se odlično slaže uz hladna predjela kao salata.
Ostavite Vaš komentar:
NAPOMENA: Komentarisanje vesti na portalu UNA.RS je anonimno, a registracija nije potrebna. Komentari koji sadrže psovke, uvrede, pretnje i govor mržnje na nacionalnoj, verskoj, rasnoj osnovi ili povodom nečije seksualne opredeljenosti neće biti objavljeni. Komentari odražavaju stavove isključivo njihovih autora, koji zbog govora mržnje mogu biti i krivično gonjeni. Kao čitatelj prihvatate mogućnost da među komentarima mogu biti pronađeni sadržaji koji mogu biti u suprotnosti sa Vašim načelima i uverenjima. Nije dozvoljeno postavljanje linkova i promovisanjedrugih sajtova kroz komentare.
Svaki korisnik pre pisanja komentara mora se upoznati sa Pravilima i uslovima korišćenja komentara. Slanjem komentara prihvatate Politiku privatnosti.
Komentari ()
- Najnovije
- Najčitanije
- Povezano

Misija Artemis II pomerila granice, ali najvažniji rekord ostao netaknut
Pre 1 h

Vučinić o reprezentaciji Srbije: "Počastvovan sam što sam ponovo ovde"
Pre 1 h

Zadovoljstvo koje može da presedne: Stručnjaci upozoravaju na opasne zamke s*ksa u vodi
Pre 1 h

Prvi snimci iPhone 18 Pro modela: Apple sprema moćan čip i jednu neočekivanu promenu
Pre 2 h

Cena kakaa skočila 22 odsto za mesec dana: Da li se iza poskupljenja krije prilika za zaradu?
Pre 2 h

Renar: "Ni sekund nisam razmišljao da li da preuzmem reprezentaciju Tunisa"
Pre 2 h

Dženifer Lopez o razvodu od Bena Afleka: "Nemam koga da krivim"
Pre 2 h